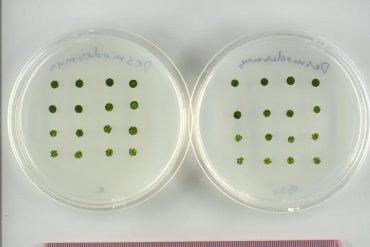

This year, the spring block of exhibitions at the Brno House of Arts (‘Dům umění’) deals with the themes of...
JoinedMay 20, 2025
Articles56
Brno is preparing for the 28th Ignis Brunensis festival, which will run from 13-25 June. As usual, the main event...
Researchers from the Institute of Chemistry and Biochemistry at Mendel University’s Faculty of Agronomy will participate in three studies taking...
From 6-20 June, the former cinema on the grounds of the Brno Exhibition Centre will showcase the many creations of...
Ghettofest, the now traditional summer festival, will once again bring together dozens of local and foreign creators and performers, turning...
On Wednesday, Brno city council approved a CZK 70 million investment plan for the reconstruction of Stara Osada, one of...
Tomorrow night, 23 May, the many churches, chapels, congregations and orders of Brno and beyond will welcome tens of thousands...
“We want to be a club that fights for Brno“, says Igor Fait, owner of the newly renamed SK Artis...
No More Content